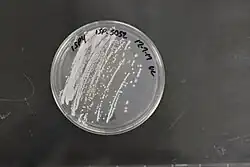

Streptomyces netropsis
| Streptomyces netropsis | |
|---|---|
| |
| Scientific classification | |
| Domain: | Bacteria |
| Kingdom: | Bacillati |
| Phylum: | Actinomycetota |
| Class: | Actinomycetes |
| Order: | Streptomycetales |
| Family: | Streptomycetaceae |
| Genus: | Streptomyces |
| Species: | S. netropsis
|
| Binomial name | |
| Streptomyces netropsis Witt and Stackebrandt 1991[1]
| |
| Type strain | |
| 2937-6, ATCC 23940, BCRC 13374, CBS 924.68, CCRC 13374, CECT 3265, CEST 3265, Chas. Pfizer & Co. 2937-6(4779), Chas. Pfizer & Co.2937(4779), Chas. Pfizer Co. 2937, CIP 108153, DSM 40259, DSMZ 40259, ETH 15974, ETH 24229, FD 4779, HUT-6086, IFM 1035, IFO 12893, IFO 3723, IPV 1720, IPV 880, IPV 889, ISP 5259, JCM 4063, JCM 4655 , KCC S-0063, KCC S-0655, KCCS-0063, KCCS-0655, KCTC 9873, LMG 5979, NBRC 12893, NBRC 3723, NCB 266, NCIB 9592, NCIB 9855, NCIMB 9592, NCIMB 9855, NRRL 2268, NRRL B, NRRL B-2268, NRRL-ISP 5259, PCM 2251, PSA 80, RIA 1184, RIA 605, Routien 4779, VKM Ac-820[2] | |
| Synonyms[3][4] | |
| |
Streptomyces netropsis is a bacterium species from the genus of Streptomyces.[1][4][3] Streptomyces netropsis produces the antibiotics netropsin and distamycin A and the antifungal polyene mycoheptin.[4][5][6][7][8][9][10]
Further reading
- Vingadassalon, Audrey; Lorieux, Florence; Juguet, Maud; Le Goff, Géraldine; Gerbaud, Claude; Pernodet, Jean-Luc; Lautru, Sylvie (20 February 2015). "Natural Combinatorial Biosynthesis Involving Two Clusters for the Synthesis of Three Pyrrolamides in". ACS Chemical Biology. 10 (2): 601–610. doi:10.1021/cb500652n. PMID 25415678.
- Vingadassalon, A; Lorieux, F; Juguet, M; Le Goff, G; Gerbaud, C; Pernodet, JL; Lautru, S (20 February 2015). "Natural combinatorial biosynthesis involving two clusters for the synthesis of three pyrrolamides in Streptomyces netropsis". ACS Chemical Biology. 10 (2): 601–10. doi:10.1021/cb500652n. PMID 25415678.
- Wang, XK; Jin, JL (August 2014). "Crucial factor for increasing the conjugation frequency in Streptomyces netropsis SD-07 and other strains". FEMS Microbiology Letters. 357 (1): 99–103. doi:10.1111/1574-6968.12507. PMID 24935520.
- Hao, Chunlin; Huang, Sheng; Deng, Zixin; Zhao, Changming; Yu, Yi; Neilan, Brett (5 June 2014). "Mining of the Pyrrolamide Antibiotics Analogs in Streptomyces netropsis Reveals the Amidohydrolase-Dependent "Iterative Strategy" Underlying the Pyrrole Polymerization". PLOS ONE. 9 (6): e99077. Bibcode:2014PLoSO...999077H. doi:10.1371/journal.pone.0099077. PMC 4047045. PMID 24901640.
- Wang, Xian-Kun; Jin, Jian-Ling (August 2014). "Crucial factor for increasing the conjugation frequency in SD-07 and other strains". FEMS Microbiology Letters. 357 (1): 99–103. doi:10.1111/1574-6968.12507. PMID 24935520.
- ed.-in-chief, George M. Garrity (2012). Bergey's manual of systematic bacteriology (2nd ed.). New York: Springer Science + Business Media. ISBN 978-0-387-68233-4.
{{cite book}}:|last1=has generic name (help) - Arya, Dev P. (2007). Aminoglycoside antibiotics from chemical biology to drug discovery. Hoboken, N.J.: Wiley-Interscience. ISBN 978-0-470-14966-9.
- Zdenko, Vanek (1965). Biogenesis of Antibiotic Substances. Burlington: Elsevier Science. ISBN 0-323-15583-9.
- Guschlbauer, edited by Wilhelm; Saenger, Wolfram (1987). DNA-ligand interactions from drugs to proteins. New York: Plenum Press. ISBN 1-4684-5383-1.
{{cite book}}:|first1=has generic name (help) - Juo, Pei-Show (2001). Concise Dictionary of Biomedicine and Molecular Biology (2nd ed.). Hoboken: CRC Press. ISBN 1-4200-4130-4.
See also
References
- ^ a b LPSN bacterio.net
- ^ Straininfo of Streptomyces netropsis
- ^ a b UniProt
- ^ a b c Deutsche Sammlung von Mikroorganismen und Zellkulturen [1]
- ^ Blake, R.D. (2004). Informational biopolymers of genes and gene expression. Sausalito, CA: University Science. ISBN 1-891389-28-9.
- ^ Krey, Anne K.; Allison, Richard G.; Hahn, Fred E. (1 January 1973). "Interactions of the antibiotic, distamycin A, with native DNA and with synthetic duplex polydeoxyribonucleotides". FEBS Letters. 29 (1): 58–62. Bibcode:1973FEBSL..29...58K. doi:10.1016/0014-5793(73)80015-8. PMID 11946908. S2CID 20205896.
- ^ al.], edited by Koji Nakanishi ... [et (1983). Natural products chemistry. Oxford: Oxford University Press. ISBN 0-935702-14-8.
{{cite book}}:|first1=has generic name (help) - ^ Collins, Peter M., ed. (2006). Dictionary of carbohydrates with CD-ROM (2nd ed.). Boca Raton: CRC/Taylor & Francis. ISBN 0-8493-7765-X.
- ^ Ékzemplyarov, O. N. (February 1977). "Mycoheptin, an antifungal antibiotic". Pharmaceutical Chemistry Journal. 11 (2): 285–289. doi:10.1007/BF00779104. S2CID 37119029.
- ^ ed. by G. Michael Blackburn (2006). Nucleic acids in chemistry and biology (3. ed.). Cambridge: RSC Publ. ISBN 0-85404-654-2.
{{cite book}}:|author=has generic name (help)